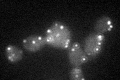
YLR332W
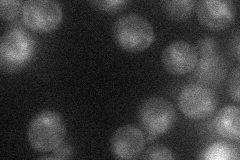
YLR332W
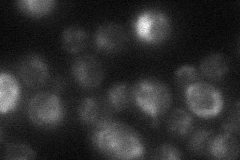
YLR332W

View description
O-glycosylated plasma membrane protein that acts as a sensor for cell wall integrity signaling and activates the pathway; interacts with Rom2p, a guanine nucleotide exchange factor for Rho1p, and with cell integrity pathway protein Zeo1p
Localization:
Intensity:
Fold change:
Significance:
-
C’ GFP library in SD
punctate25.08 -
N' NOP1pr-GFP in SD
vacuole19.6997 -
N' TEF2pr-mCherry in SD

below threshold0 -
N' NATIVEpr-GFP in SD
vacuole22.8839 -
N' TEF2pr-VC and Cyto-VN in SD

#N/A0 -
C’ GFP library in SD+DTT

punctate26.481.05No -
C’ GFP library in SD+H2O2

punctate25.341.01No -
C’ GFP library in Starvation Media

punctate33.171.32No -
C’ GFP library on the background of Pup2-DaMP

punctate -
C’ GFP library on the background of CCT mutant

punctateN/AN/ANo
